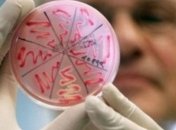
В одной из школ Ужгорода обнаружили менингококковую инфекцию

Новости по теме Ужгород
-

Лидер союза венгров: к теракту в Ужгороде привела антивенгерская кампания в Украине.
-

"Железнодорожная компания Словакии" заинтересована в запуске пассажирского поезда Ужгород-Кошице с последующим продолжением маршрута до Братиславы и Праги.
-

Двухдневный гастрономический фестиваль "МедовухаФест", посвященный продуктам пчеловодства, в частности легендарной закарпатской медовухе, прошел в Ужгороде.
-

Союз венгров в Ужгороде подожгли пророссийские боевики из ЕС, их имена известны.
-

Супруга Президента Украины Марина Порошенко в Ужгороде приняла участие в открытии первого инклюзивно-ресурсного центра образования на Закарпатье.
-

В Ужгороде из горящего общежития спасатели эвакуировали 300 и спасли 12 человек – ГСЧС
-

Представительства МИД Украины в Ужгороде возобновит работу.
-

В МИД Венгрии ожидают от властей Украины гарантий безопасности закарпатских венгров.
-
В Ужгороде в школе №12 зафиксированы три случая заболевания менингококковой инфекцией.
-

Верховный комиссар ОБСЕ по вопросам нацменьшинств Заньер посетит Ужгород .
-

Павел Климкин отреагировал на инцидент в здании венгерского сообщества в Ужгороде.
-

Огонь успел повредить часть служебной документации, офисную мебель и оргтехнику.
-

Гражданин Грузии с диппаспортом пытался провезти в ЕС 45 ящиков контрабандных сигарет.
-

Американцы и словаки решили пробурить в Украине первую совместную газовую скважину
-

Геннадий Москаль анонсирует начало реставрационных работ на Невицком замке под Ужгородом.
-

Государственная пограничная служба Украины заявила о задержании четырех сенегальцев, которые пытались незаконно пересечь границу.

